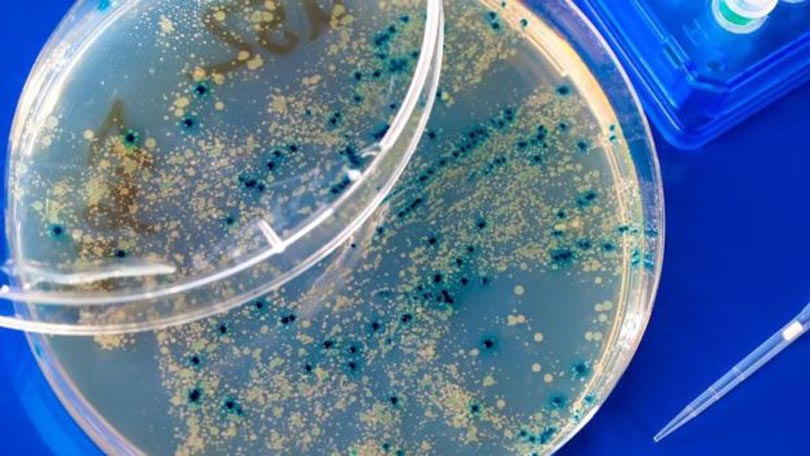

हिन्दु धर्माबलम्बीहरुले गंगा नदीको पानीलाई पवित्र जलको रुपमा प्रयोग गर्ने गरेका छन् । गंगाको पानी पवित्र हुनका साथै स्वच्छ पनि छ । गंगाको पानी फोहोर नहुनका साथै यसमा किरा पनि पर्दैन । साथै, यसको पानीबाट दुर्गन्ध आउँदैन ।
गंगाको पानी मानिसको अन्यायको शिकार हुनु परेको छ । पानीमा लास, नाली, फोहोरलगायत मानबजन्य बिकार फाल्ने गरिएको छ । तर, पनि पानीको ताजापनमा कुनै परिवर्तन आएको छैन ।
गंगामा के राज छ ?
गंगाको पानी सदा शुद्ध हुनुको राज हो भाइरस । गंगा नदीमा यस्तो किसिमको भाइरस छ, जसले पानीमा कुनै पनि वस्तुलाई कुहिन दिदैन ।
कुरा करिब सवा सय बर्ष पुरानो हो । सन् १८९० को दशकमा बेलायतका वैज्ञानिक अर्नेस्ट हैकिन गंगाको पानीमा अनुसन्धान गर्दै थिए । त्यो समय भारतभर झाडापखलाको प्रकोप फैलिएको थियो । मानिसहरुले लासलाई गंगा नदीमा बगाउने गर्थे ।
हैकिनलाई डर थियो कि गंगामा नुहाउने अन्य व्यक्तिलाई पनि झाडापखला लाग्न सक्छ भन्ने । तर, त्यस्तो केही भएन ।
हैकिन अचम्मित भए । किनकि उनले यूरोपको प्रदुषित पानी पिउनाका कारण मानिस बिरामी भएका देखेका थिए । गंगाको पानीको चामत्कारिक असरबाट उनी अचम्मित हुनु पर्यो ।
निन्जा भाइरस
हैकिनको सो अनुसन्धानलाई २० बर्षपछि एक फ्रेन्च वैज्ञानिकले अगाडि बढाए । ती वैज्ञानिकले अनुसन्धानबाट गंगाको पानीमा पाइने भाइरसले झाडापखला फैलाउने ब्याक्टेरिया भित्र पसेर त्यसलाई नष्ट गरेको नयाँ तथ्य फेला पर्यो ।
त्यो भाइरस गंगाको पानीको शुद्धता कायम राख्नका लागि जिम्मेवार थियो । भाइरसका कारण नदीमा नुहाउने मानिसमा झाडापखाला फैलिन सकेन ।
ब्याक्टेरियालाई तह लगाउने यो भाइरस मानिसका लागि निकै उपयोगी हुन सक्ने अध्ययनहरुले देखाएका छन् । २१ औं शताब्दीका अनुसन्धानकर्ताहरुले यसलाई निन्जा भाइरसको नाम दिएका छन् ।
करिब एक शताब्दी पहिला मेडिकल दुनियामा एन्टीवायोटिकका कारण क्रान्ति आएको थियो । चोट, घाउ वा बिरामीबाट मुत्युवरण गर्ने व्यक्तिका लागि एन्टीबायोटिक वरदान बन्न पुग्यो । यसका मद्दतबाट कयौं व्यक्ति अकाल मुत्युबाट बच्न सकेका छन् ।
हालका दिनमा कयौं ब्याक्टेरिया एन्टीबायोटिक प्रभावहिन हुने गरेको छ । अहिले संसारभरका हजारौं मानिस यस्तो ब्याक्टेरियाबाट मर्ने गरेका छन् ।
सन् २०१४ को एक रिपोर्ट अनुसार, सन् २०५० सम्म एन्टीबायोटिकका प्रभाव न्युन हुन्छ । जसका कारण १ करोड मानिस ब्याक्टेरियाका कारण मर्नेछन् । यो संख्या भनेको अहिले क्यान्सरबाट मर्ने जति नै हो ।
खतरनाक ब्याक्टेरिया मार्ने भाइरस
एन्टीबायोटिकको प्रभाव कम भएमा साधारण चोटबाट पनि मानिसको मुत्यु हुन्छ । जस्तै १८ औ तथा १९ औं शताब्दीमा हुने गरेको थियो । युद्धमा सामान्य चोटपटक लाग्ने व्यक्तिहरु पनि मर्ने गर्थे ।
यस प्रकारको हालतबाट बच्नका लागि गंगामा उपलब्ध भाइरस सहयोगी हुनसक्छ । यो भाइरस प्राकृर्तिक रुपमा उपलब्ध छ । संसारभर छरिएर रहेका मानिसको संख्याभन्दा एक ग्राम माटोमा उपलब्ध हुने भाइरसको संख्या धेरै हुन्छ ।
ती मध्ये कोही भाइरसले ब्याक्टेरियालाई आक्रमण गरेर मार्छ । यो भाइरसको गुण भनेको यसले सबै ब्याक्टेरियालाई आक्रमण गर्दैन । यसले मानिसलाई असर पुर्याउने केही किटाणुलाई मात्र आक्रमण गर्छ ।
यस्तो भाइरस मानिसकालाई बहु–उपयोगी हुन सक्छ । यो एन्टीबायोटिकको विकल्प हुन सक्छ । न्यूजिल्याण्डका हिदर हेड्रिक्सन निन्जा भाइरस माथि अनुसन्धान गरिरहेका छन् ।

हिदर हेड्रिक्सन भन्छन्, ‘एन्टीबायोटिक रेसिस्टेन्ट ब्याक्टेरियाको डर बढ्दै गएको छ, हामी एन्टीबायोटिक अघिको समयमा पुनः जादै छौं ।’
हेड्रिक्सनका अनुसार यदि हामीलाई यस्तो हालतबाट बच्नका लागि निन्जा भाइरस माथि काम अगाडि बढाउन अवश्यक छ । उनी आफ्ना केही साथीहरुको साथ लिएर भाइरसको सूची तयार गर्दैछन्, जसले ब्याक्टेरियालाई मार्ने काम गर्छ ।
एन्टीबायोटिकको आवश्यकता छैन ?
यो भाइरस साधरण किसिमको छ । यो प्रोटिनबाट बन्छ । यसले ब्याक्टेरियामाथि आक्रमण गरेर उसको डीएनए मासेर आफ्नो संख्या बढाउन प्रयोग गर्छ ।
विस्फोट गरेर सो भाइरसले ब्याक्टेरियाको अन्त्य गर्छ । यस्तो भाइरसले ब्याक्टेरियाको खास नस्ललाई आफ्नो शिकार बनाउँछ ।
एन्टीवायोटिक भनेको एटम बम हो, जसले हानिकारक ब्याक्टेरियाका साथै असल ब्याक्टेरियालाई पनि मार्छ ।
तर, निन्जा भाइरसले केबल त्यही बैक्टीरियालाई मार्छ, जसले रोग फैलाउँछ । पश्चिमी देशका लागि यो अनुसन्धान नयाँ हो ।
तर, पूर्वी यूरोपीय देशमा लामो समयदेखि यस प्रकारका भाइसरको मद्दतले बिमारीको उपचार गर्ने गरिएको छ । उनीहरुको अनुसन्धान अंग्रेजीमा प्रकाशित नभएकाले बाँकी दुनियाले यसबारे जानकारी पाउन सकेका छैनन् ।
हिदर हेड्रिक्सनका अनुसार जर्जिया, रुस र पोल्याण्डका वैज्ञानिकले यस प्रकारको भाइरसमा धेरै अनुसन्धान गरेका छन् । जसले ब्याक्टेरियाको अन्त्य गर्छ । ती देशले यस्ता प्रभावकारी भाइरसको सूची तयार गरेका छन् ।
ब्याक्टेरियाको यमदूत
हिदर हेड्रिक्सन पनि आफ्नो ल्याबमा यस प्रकारको भाइरसको सूची तयार गर्दैछन् । जसले एन्टीबायोटिको स्थान लिन सक्छ । जसले रोगको किटाणु मार्नका लागि सहयोग गर्न सक्छ ।
केही देशमा निन्जा भाइरस सहितको ब्यान्डेज तयार गरिएको छ । यसबाट भाइरसले घाउ ठिक हुन्छ कि हुँदैन भन्ने जान्न खोजिएको छ ।
हिदर हेड्रिक्सनले एउटा घटना स्मरण गर्दै भने ‘एल्फ्रेड गर्टलर नामको एक मानिसलाई पहाड चढ्ने क्रममा घुडामा चोट लाग्यो । उनको चोट कुनै पनि एन्टीबायोटिकबाट ठिक हुन सकेन । यस्तो लागिरहेको थियो कि खुट्टा काट्नु नै एक विकल्प बाँकी छ । त्यस समय प्रयोगका लागि उनको घाउमा निन्जा भाइरस हालियो । त्यो भाइरस घाउमा रहेका ब्याक्टेरियाका लागि यमदूत थिए । १० दिनभित्रमा एल्फ्रेडको घाउ निको भयो ।’
अब ब्याक्टेरियालाई भाइरसले तह लगाउँछ । बिमारी फैलाउने बैक्टीरियाका लागि भाइरस यमदूतको सेना तयार हुदैछ ।
नेपालका विभिन्न नदीहरुको पानी पनि पवित्र मानिन्छ । यी पवित्र नदी वा ताल तलाउको पानीमा पनि यस्तै उपयोगी भाइरस हुन सक्छन् । तर, हामी नेपालीले अनुसन्धान त गरेका छैनौं नै, बिदेशीले पनि पवित्र मानिएको जलमाथि अनुसन्धान गरेका छैनन् ।
बीबीसी हिन्दीको सहयोगमा






प्रतिक्रिया